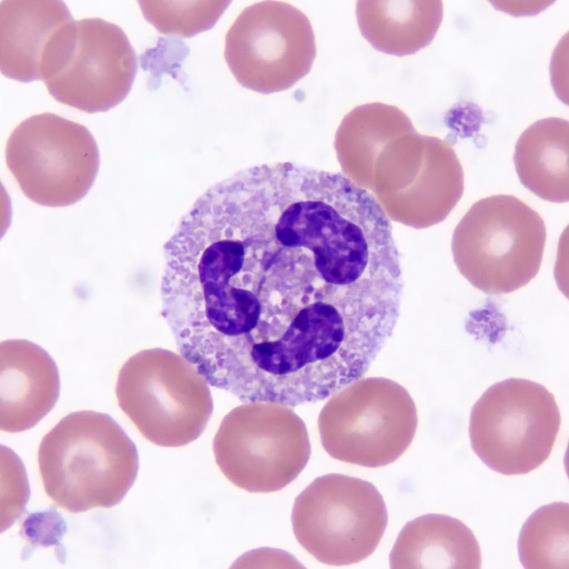
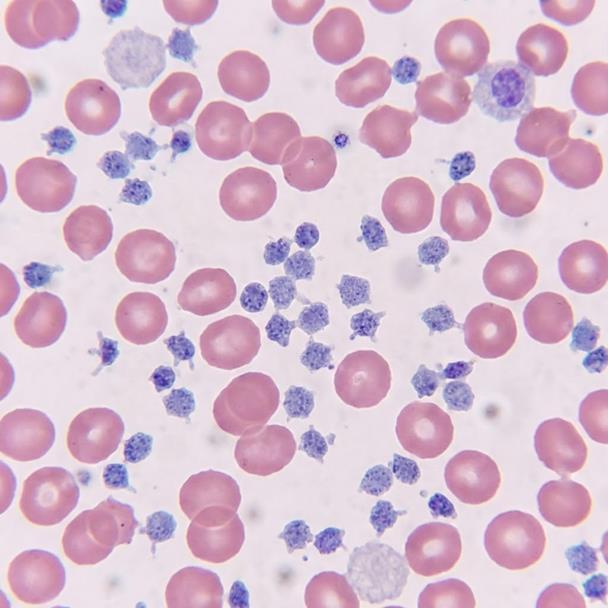

![]()






















循環系統就像城市的物流網路,
負責把氧氣與養分送達全身,並載走廢物!



心臟是一個充滿肌肉的器官,位於胸腔中央偏左。它 負責產生強大的動力,將血液打向全身血管。 • 收縮:將血液擠出去。
• 舒張:讓血液流回來。


左心房/室

負責接收充滿氧氣的血液,並將其送往全身各
個角落。
右心房/室

負責接收全身回來、帶有廢物的血液,並將其
送往肺部換氣。




氣體工廠:肺臟


肺臟是負責「換氣」的核心。我們吸入氧氣,呼
出二氧化碳與水蒸氣。
肺部充滿了無數個微小的肺泡,增加換氣的接觸 面積。

製作步驟:模型組裝
1、將2個小氣球分別套在黃色支氣管上。
2、將黃色氣管緊緊卡在胸腔模型上,確保不漏氣。
3、在模型底部套上大氣球(代表橫膈膜)。



學習活動:心臟與血管解剖觀察



豬心的構造與人類非常相似,是觀察大型器官結構的 最佳教材。請重點觀察心臟的內部隔間。



觀察:心臟的瓣膜與腱索。
比較:左右心室的空間與厚度。
連接:觀察進出心臟的主動脈與肺動脈。
示範影片




雖然雞心比豬心小很多,但其功能性構造卻毫不遜色 !適合用於小規模精細觀察。




解剖:沿著中線垂直剪開心臟。
觸摸:感受心室肌肉壁的韌性。
紀錄:標示出心房、心室與連接管路。




為什麼左心室最厚?
在解剖中我們發現,左心室的肌肉層比右心室厚三倍


左心室負責將充氧血「打到全身」,包括遙遠 的腳尖。這需要強大的收縮壓力,因此必須具 備最發達的肌肉組織。


守護健康,從「心」開始

多喝水、均衡飲食、規律運動,
讓我們一起照顧體內的超級英雄!



